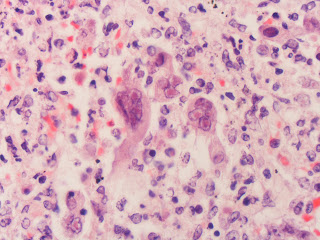

Antibiotik; Membunuh Bakteri atau Menciptakan Superbug?
Semakin kita bergantung kepada antibiotik, maka akan semakin banyak tercipta secara alami strain (turunan) baru dari bakteri yang kebal terhadap antibiotik tersebut. inilah yang disebut superbug. Perang antara perusahaan obat dengan virus dan bakteri adalah perang yang tiada akhir dan hanya membuat situasi bertambah buruk dari waktu ke waktu
Pneumonia bukanlah penyakit yang berbahaya. Ini adalah kondisi pernapasan di mana ada infeksi di paru-paru, dan dapat disebabkan oleh virus, bakteri atau bahkan dengan sengaja bernapas dalam cairan. Namun demikian, relatif mudah untuk mengobatinya dengan antibiotik dan istirahat di tempat tidur, penyakit ini jarang membuat orang sampai dikirim ke rumah sakit, dan tingkat kematian dari penyakit ini tidak tinggi. Bahkan, penyakit ini hanya cenderung menjadi fatal jika terjadi komplikasi.
NAMUN, Carbapenem-Resistance Klebsiella Pneumonia atau CRKP adalah masalah lain. Ini adalah turunan dari pneumonia yang diperoleh di rumah sakit yang telah menjadi resisten terhadap hampir semua antibiotik yang saat ini digunakan untuk mengobati kondisi tersebut. Jika itu tidak cukup buruk, bakteri Klebsiella menghasilkan enzim yang mendegradasi antibiotik kuat dan menganugerahkan resistansi tingkat rendah kepada yang lain. Dan yang membuatnya lebih buruk lagi, enzim ini dapat dikirimkan ke bakteri lain dalam tubuh.

Selama periode Oktober 2005 - Oktober 2008, sebuah rumah sakit pelatihan universitas mempelajari kasus CRKP, dan menemukan bahwa orang yang terserang superbug ini, cenderung pada orang yang menghabiskan waktunya dalam perawatan intensif dan menghabiskan lebih banyak waktu pada ventilator daripada orang yang tidak terinfeksi. Mungkin hal yang paling menakutkan dari temuan mereka adalah adalah bahwa tingkat kematian orang yang terinfeksi dengan strain pneumonia ini adalah 50%.
Mungkin ini salah satu superbug yang terkenal, bakteri ini selalu menjadi headline surat kabar lokal ketika muncul di rumah sakit rumah sakit di seluruh dunia. Staphylococcus Aureus adalah lebih umum daripada yang diperkirakan, yang terbawa pada kulit atau di dalam lubang hidung atau tenggorokan. Dalam bentuk ini, bakteri ini menyebabkan infeksi kulit ringan yang mudah diobati jika masuk ke luka pada kulit, bagaimanapun, hal-hal yang jauh lebih buruk bisa terjadi
Jika - strain MRSA Staphylococcus aureus - masuk ke aliran darah dapat mencapai dan menginfeksi hampir setiap bagian tubuh. Keracunan darah, paru-paru dan jantung infeksi dan abses di dalam tubuh, semua adalah komplikasi umum setelah seseorang terinfeksi. Pengobatan saat ini adalah campuran dari jenis antibiotik, tetapi pasti akan memakan waktu beberapa minggu untuk untuk pulih.

Apa yang membuat bakteri ini begitu berbahaya adalah fakta bahwa bakteri ini kebal terhadap hampir semua antibiotik. Menyebar dengan mudah lewat kontak fisik, dan baru-baru ini wabah MRSA di masyarakat jauh dari rumah sakit telah terjadi. Hal ini dapat disebabkan oleh fakta bahwa sejumlah besar penduduk, sekitar 2%, membawa strain Staphylococcus Aureus yang resisten terhadap antibiotik . Angka kematian tiga puluh hari telah terlihat setinggi 30%.
Biasanya satu-satunya waktu Anda mendengar tentang Escherichia coli, atau E. Coli, adalah ketika Anda atau seseorang yang Anda kenal menderita kasus keracunan makanan. Sebuah demam ringan, mual, muntah dan diare adalah gejala utama yang terjadi ketika tubuh terinfeksi E. Coli. Meskipun tidak enak jika anda mengalaminya, tapi hal ini tidak berbahaya kecuali jika Anda sangat tua atau sangat muda.
Namun, awal tahun ini strain virulen E. Coli melanda Jerman. Sebelas negara terkena, 2.000 orang terinfeksi dan ada 18 kematian akibat infeksi ini. Meskipun tingkat kematian yang tidak buruk dibandingkan dengan superbug lainnya (yang kurang lebih sama dengan angka kematian yang normal), apa yang membuat strain baru ini begitu berbahaya adalah risiko yang terkait sindrom uremik hemolitik atau HUS sebagai komplikasi. Lebih dari 500 kasus telah dilaporkan di Jerman sejauh ini, yang merupakan 25% dari tingkat infeksi sekunder.

Sindrom uremik hemolitik dominan terlihat pada anak, tapi ketika itu terjadi pada orang dewasa, gejala-gejala bisa buruk. Biasanya pasien akan menjadi kuning dan atau anemia. Tekanan darah tinggi, kencing berdarah dan gejala sistem saraf juga dapat berkembang. Dalam 25% dari kasus orang dengan HUS akan menderita kerusakan ginjal dan tekanan darah tinggi. Dalam 5% kasus pasien akan mati. Jadi jika resistance E. Coli tidak membuat Anda mati, bisa jadi infeksi sekunder yang melakukannya.
Bakteri ini dianggap sebagai penerus MRSA oleh beberapa dokter. Seperti banyak infeksi yang didapat di rumah sakit, Acinetobacter baumanii akan memasuki tubuh manusia melalui luka terbuka pada tubuh, dan dari sana akan mendatangkan malapetaka pada tubuh.
Sebelum 2003 infeksinya relatif jarang, tetapi pada tahun 2003 sejumlah besar tentara yang terluka kembali dari Irak ditemukan memiliki infeksi Acinetobacter baumanii. diperkirakan bahwa infeksi terjadi dari tanah, di mana bakteri dapat tinggal, dan dibawa kembali ke rumah sakit dengan cedera. Hal ini mengakibatkan kontaminasi silang dalam cara yang mirip dengan MRSA, dan akhirnya muncul pada warga sipil.
Apa yang membuat bakteri ini berbahaya adalah fakta bahwa ia dapat mempengaruhi Anda dalam berbagai cara. Jika menyerang kulit, maka bakteri ini akan mempengaruhinya seperti nekrotikans necrotising, penyakit pemakan daging yang sangat buruk yang benar-benar dapat memakan penderitanya sampai mati jika tidak diobati. Jika menyerang paru-paru, pasien bisa mendapatkan pneumonia. pada kenyataannya, Acinetobacter baumanii dapat menyebabkan infeksi hampir di mana saja.

Lebih buruknya lagi, Lima puluh lima persen dari semua bakteri baumanii A. yang ditemukan di rumah sakit, menjadi resisten terhadap tiga jenis antibiotik, dan 17% ditemukan resisten terhadap empat jenis - yang bisa berarti bahwa resistensi bakteri masih bisa berkembang. Hal ini juga dua kali lebih mungkin mengotori pakaian kesehatan pekerja dan sarung tangan seperti MRSA, yang berarti menyebar lebih cepat dan lebih mudah. Bakteri ini juga memiliki tingkat kematian hingga 50%, membuat bakteri ini menjadi salah satu bakteri yang sangat menakutkan.
Kebanyakan superbug biasanya langka. Infeksi terbaru untuk menjadi resisten terhadap obat, bagaimanapun, adalah sangat umum. Gonorrhoea adalah salah satu penyakit menular seksual yang paling luas saat ini. Penyakit ini dapat terjadi dengan memiliki segala jenis hubungan seks yang tidak aman, dan pada beberapa orang, gejalanya bahkan tidak muncul, sehingga kemungkinan akan diteruskan. Gejala dapat berkisar dari sakit tenggorokan sederhana sampai ke infertilitas.
Sebanyak 700.000 orang di Amerika Serikat saja, dipercaya mendapatkan Gonorrhoea, dengan seorang wanita hanya memiliki kemungkinan 50% untuk menunjukkan gejala. Setelah Gonorrhoea telah diobati dan telah pergi, penyakit tersebut dapat datang lagi, artinya tidak ada kekebalan tubuh yang dibuat bahkan setelah penyakit disembuhkan.

Apa yang membuat strain baru Gonorrhoea ini begitu berbahaya bukanlah risiko kematian, melainkan risiko tidak pernah mampunya untuk menyingkirkan infeksi. Semakin lama Anda memiliki infeksi, semakin besar kemungkinan infeksi sekunder yang parah. Infertilitas, kehamilan ektopik dan pembengkakan skrotum bisa menjadi bertambah besar kemungkinannya. Kalau itu tidak cukup buruk, ada kemungkinan mewariskan kondisi ini pada bayi yang dilahirkan selama persalinan.
5. Carbapenem-resistant Klebsiella pneumoniae (CRKP)

NAMUN, Carbapenem-Resistance Klebsiella Pneumonia atau CRKP adalah masalah lain. Ini adalah turunan dari pneumonia yang diperoleh di rumah sakit yang telah menjadi resisten terhadap hampir semua antibiotik yang saat ini digunakan untuk mengobati kondisi tersebut. Jika itu tidak cukup buruk, bakteri Klebsiella menghasilkan enzim yang mendegradasi antibiotik kuat dan menganugerahkan resistansi tingkat rendah kepada yang lain. Dan yang membuatnya lebih buruk lagi, enzim ini dapat dikirimkan ke bakteri lain dalam tubuh.

Selama periode Oktober 2005 - Oktober 2008, sebuah rumah sakit pelatihan universitas mempelajari kasus CRKP, dan menemukan bahwa orang yang terserang superbug ini, cenderung pada orang yang menghabiskan waktunya dalam perawatan intensif dan menghabiskan lebih banyak waktu pada ventilator daripada orang yang tidak terinfeksi. Mungkin hal yang paling menakutkan dari temuan mereka adalah adalah bahwa tingkat kematian orang yang terinfeksi dengan strain pneumonia ini adalah 50%.
4. Methicillin Resistant Staphylococcus Aureus (MRSA)

Jika - strain MRSA Staphylococcus aureus - masuk ke aliran darah dapat mencapai dan menginfeksi hampir setiap bagian tubuh. Keracunan darah, paru-paru dan jantung infeksi dan abses di dalam tubuh, semua adalah komplikasi umum setelah seseorang terinfeksi. Pengobatan saat ini adalah campuran dari jenis antibiotik, tetapi pasti akan memakan waktu beberapa minggu untuk untuk pulih.

Apa yang membuat bakteri ini begitu berbahaya adalah fakta bahwa bakteri ini kebal terhadap hampir semua antibiotik. Menyebar dengan mudah lewat kontak fisik, dan baru-baru ini wabah MRSA di masyarakat jauh dari rumah sakit telah terjadi. Hal ini dapat disebabkan oleh fakta bahwa sejumlah besar penduduk, sekitar 2%, membawa strain Staphylococcus Aureus yang resisten terhadap antibiotik . Angka kematian tiga puluh hari telah terlihat setinggi 30%.
3. Resistant E. Coli

Namun, awal tahun ini strain virulen E. Coli melanda Jerman. Sebelas negara terkena, 2.000 orang terinfeksi dan ada 18 kematian akibat infeksi ini. Meskipun tingkat kematian yang tidak buruk dibandingkan dengan superbug lainnya (yang kurang lebih sama dengan angka kematian yang normal), apa yang membuat strain baru ini begitu berbahaya adalah risiko yang terkait sindrom uremik hemolitik atau HUS sebagai komplikasi. Lebih dari 500 kasus telah dilaporkan di Jerman sejauh ini, yang merupakan 25% dari tingkat infeksi sekunder.

Sindrom uremik hemolitik dominan terlihat pada anak, tapi ketika itu terjadi pada orang dewasa, gejala-gejala bisa buruk. Biasanya pasien akan menjadi kuning dan atau anemia. Tekanan darah tinggi, kencing berdarah dan gejala sistem saraf juga dapat berkembang. Dalam 25% dari kasus orang dengan HUS akan menderita kerusakan ginjal dan tekanan darah tinggi. Dalam 5% kasus pasien akan mati. Jadi jika resistance E. Coli tidak membuat Anda mati, bisa jadi infeksi sekunder yang melakukannya.
2. Resistant Acinetobacter Baumannii

Sebelum 2003 infeksinya relatif jarang, tetapi pada tahun 2003 sejumlah besar tentara yang terluka kembali dari Irak ditemukan memiliki infeksi Acinetobacter baumanii. diperkirakan bahwa infeksi terjadi dari tanah, di mana bakteri dapat tinggal, dan dibawa kembali ke rumah sakit dengan cedera. Hal ini mengakibatkan kontaminasi silang dalam cara yang mirip dengan MRSA, dan akhirnya muncul pada warga sipil.
Apa yang membuat bakteri ini berbahaya adalah fakta bahwa ia dapat mempengaruhi Anda dalam berbagai cara. Jika menyerang kulit, maka bakteri ini akan mempengaruhinya seperti nekrotikans necrotising, penyakit pemakan daging yang sangat buruk yang benar-benar dapat memakan penderitanya sampai mati jika tidak diobati. Jika menyerang paru-paru, pasien bisa mendapatkan pneumonia. pada kenyataannya, Acinetobacter baumanii dapat menyebabkan infeksi hampir di mana saja.

Lebih buruknya lagi, Lima puluh lima persen dari semua bakteri baumanii A. yang ditemukan di rumah sakit, menjadi resisten terhadap tiga jenis antibiotik, dan 17% ditemukan resisten terhadap empat jenis - yang bisa berarti bahwa resistensi bakteri masih bisa berkembang. Hal ini juga dua kali lebih mungkin mengotori pakaian kesehatan pekerja dan sarung tangan seperti MRSA, yang berarti menyebar lebih cepat dan lebih mudah. Bakteri ini juga memiliki tingkat kematian hingga 50%, membuat bakteri ini menjadi salah satu bakteri yang sangat menakutkan.
1. Antibiotic Resistant Neisseria Gonorrhoea
Sebanyak 700.000 orang di Amerika Serikat saja, dipercaya mendapatkan Gonorrhoea, dengan seorang wanita hanya memiliki kemungkinan 50% untuk menunjukkan gejala. Setelah Gonorrhoea telah diobati dan telah pergi, penyakit tersebut dapat datang lagi, artinya tidak ada kekebalan tubuh yang dibuat bahkan setelah penyakit disembuhkan.

Apa yang membuat strain baru Gonorrhoea ini begitu berbahaya bukanlah risiko kematian, melainkan risiko tidak pernah mampunya untuk menyingkirkan infeksi. Semakin lama Anda memiliki infeksi, semakin besar kemungkinan infeksi sekunder yang parah. Infertilitas, kehamilan ektopik dan pembengkakan skrotum bisa menjadi bertambah besar kemungkinannya. Kalau itu tidak cukup buruk, ada kemungkinan mewariskan kondisi ini pada bayi yang dilahirkan selama persalinan.
Posting Komentar untuk "Antibiotik; Membunuh Bakteri atau Menciptakan Superbug?"